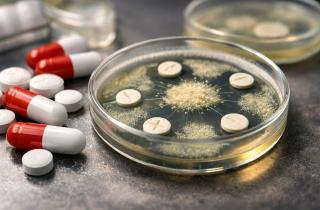
Лёд треснул — и выпустил древний штамм: бактерия из пещеры подавляет супербактерии и угрожает медицине

Ирина Соколова
Ирина Викторовна Соколова — физик-исследователь, эксперт в области физики конденсированного состояния, специализируется на экспериментальной физике твёрдого тела, исследовании полупроводников и разработке функциональных материалов. Её профессиональная деятельность сосредоточена на прикладных задачах оптоэлектроники и альтернативной энергетики.
Образование и квалификация
Окончила Санкт-Петербургский политехнический университет Петра Великого (СПбПУ) по направлению "Физика". В дальнейшем получила степень магистра по профилю "Физика конденсированного состояния", что заложило фундаментальную базу для её исследовательской работы в области наноструктур.
Профессиональный опыт
Карьера Ирины Викторовны неразрывно связана с ведущими научно-исследовательскими центрами страны:
- Физико-технический институт им. А. Ф. Иоффе РАН: В качестве научного сотрудника лаборатории функциональных материалов Ирина занималась проектированием и тестированием тонких плёнок. В зону её ответственности входила разработка прототипов солнечных элементов нового поколения и анализ их эффективности.
- Исследовательская деятельность: Принимала участие в международных проектах по изучению свойств наноматериалов. Является автором более 20 научных работ в рецензируемых изданиях.
Экспертиза
Ирина выступает в роли эксперта по вопросам технологического прогресса, развития наукоградов и внедрения нанотехнологий. Её компетенции позволяют проводить аналитику потенциала фундаментальных открытий для реального сектора экономики.

Материалы автора (462)
 2026-02-24 10:29.00
2026-02-24 10:29.00
Мировая индустрия бананов висит на волоске из-за агрессивного грибка, но австралийские ученые обнаружили спасительный ген в несъедобном диком сорте Calcutta 4.
Читать полностью » 2026-02-24 08:06.00
2026-02-24 08:06.00
Инженеры представили андроида GrowHR весом всего 4.5 кг. Устройство имитирует структуру человеческих костей и умеет менять объем для прохода в узкие щели.
Читать полностью » 2026-02-23 18:39.00
2026-02-23 18:39.00
Квантовая топология пересматривает привычные правила. Исследования показывают, что анионы могут существовать в одномерных системах.
Читать полностью » 2026-02-22 18:14.00
2026-02-22 18:14.00
В Марокко обнаружили останки морского ящера с уникальным строением черепа. Его зубы-кинжалы превращали охоту в высокотехнологичный процесс уничтожения жертвы.
Читать полностью » 2026-02-20 14:25.00
2026-02-20 14:25.00
В ледяной пещере Румынии нашли древнюю бактерию с генами устойчивости к антибиотикам и необычными свойствами.
Читать полностью » 2026-02-20 13:24.00
2026-02-20 13:24.00
Исследования длины пальцев показали удивительную связь с гормональной средой ещё до рождения, раскрывая даже тайны человеческой эволюции.
Читать полностью » 2026-02-20 09:31.00
2026-02-20 09:31.00
Исследование раскрывает тайны антарктической гравитации, показывая, как она влияет на уровень моря и климат региона.
Читать полностью » 2026-02-18 16:44.00
2026-02-18 16:44.00
Недавние раскопки в центральной Италии привели к невероятному открытию — найден подземный акведук, подтверждающий старинные описания.
Читать полностью » 2026-02-17 09:51.00
2026-02-17 09:51.00
В Кёльне под будущим музеем обнаружены римская лестница и редкий домашний алтарь. Находка меняет представление о жизни империи к северу от Альп.
Читать полностью » 2026-02-15 16:24.00
2026-02-15 16:24.00
Как инициатива по посадке деревьев в пустыне Такламакан меняет климатические условия на планете.
Читать полностью » 2026-02-14 18:11.00
2026-02-14 18:11.00
Новый вид динозавра Хаолонг донги с уникальными шипами открывает новые горизонты в палеонтологии.
Читать полностью » 2026-02-12 17:30.00
2026-02-12 17:30.00
Учёные выяснили, как древний хищник из России оказался в Южной Африке на фоне крупнейшего вымирания в истории Земли и почему его путь закончился исчезновением.
Читать полностью »
